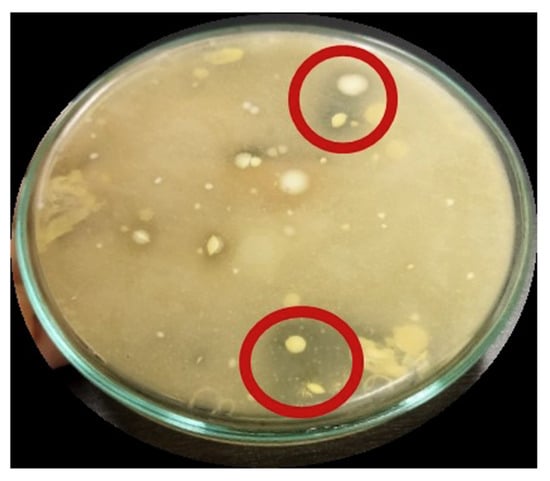

Abstract
Beef is a perishable food that can be naturally preserved using antimicrobial chemicals in a procedure known as biopreservation. Probiotic bacteria, or bacteria with the ability to create antimicrobial metabolites, are known as lactic acid bacteria. Fermented foods such as dadih, or fermented buffalo milk, from West Sumatra, Indonesia, contain lactic acid bacteria. This study aims to explore the existence of probiotic lactic acid bacteria in dadih and the effectiveness of utilizing lactic acid bacteria metabolites as biopreservatives in beef for nine days at 4 °C. The DK1 strain of lactic acid bacteria showed the most antibacterial metabolite activity against Salmonella sp. (11.5 mm) and Escherichia coli (13 mm) among the three isolates examined. Probiotic characteristics set the DK1 isolate apart; resistance test results showed over 106 CFU/mL, pH 2–4, a temperature range of 25 °C to 45 °C, and 0.3% bile salt. DK1 isolates tested positive for auto-aggregation 89.2% of the time. The co-aggregation test results for Salmonella sp. and E. coli reveal 46.9% and 53.1%, respectively. The findings of the bio preservation showed that, overall, treated beef contained fewer E. coli and other microorganisms than untreated meat. Furthermore, compared to control beef, metabolite-treated meat showed a shift in hue and a lower, more constant pH value.
1. Introduction
Beef is one of the protein-rich foods that is prone to pathogenic bacteria contamination because it contains high levels of water and nutrient content, so that beef is also considered as a cause of foodborne disease [1]. After slaughtering process, this contamination could occur during handling and storage processes, and it is mainly caused by Salmonella sp., Escherichia coli O157:H7, Campylobacter jejune, Listeria monocytogenes, Clostridium perfringens, Bacillus cereus, C. botulinum, Yesinia enterocolitica, and Staphylococcus aureus [2]. To preserve beef products, many industries often use chemicals or physical treatments [3]. Chemicals such as nitrates are frequently used, but they can easily be converted to nitrite compounds which can produce nitrosamines as a carcinogen [4]. Furthermore, when ingested, nitrite compounds can trigger methemoglobin production which is the cause of methemoglobinemia. In addition, physical treatments such as freezing can be an alternative way to inhibit microbial growth, but this method also has negative effects on physical and sensory beef quality. During frozen storage, meat’s capacity to retain water will be reduced, which will change the structure of muscles and the beef’s suppleness. Moreover, myoglobin in beef is quickly oxidized, so the color of the beef will be diminished [5]. Defrosting is also considered to affect beef quality under improper conditions by triggering higher levels of microbial contamination [6].
Biopreservation is an approach to extend the shelf life of foods by exploiting biological systems, such as lytic bacteriophages, lactic acid bacteria and their metabolites, and bacteriocins, that have antagonistic activities to inhibit or destroy undesired microorganisms in foods. Biopreservation has been developed as a promising antimicrobial technology in improving safety of foods with extended shelf life. Lactic acid bacteria (LAB) are potentially utilized in biopreservation because they are recognized as safe microorganisms and naturally act as probiotics that produce a range of metabolites with antimicrobial activities [7]. Postbiotics or cell-free supernatants (CFS) are liquids with inactivated microbial cells containing bacterial metabolites, such as antimicrobial peptides (bacteriocin), organic acids, and hydrogen peroxide. As antimicrobial agents, these metabolites are also known as bioactive compounds which are able to inhibit spoilage by suppressing the growth of foodborne pathogens [8,9]. In addition, LAB with their metabolites also contribute to improve the flavor, color, and texture of foods by attenuating chemical reactions, such as lipid oxidation [1,10]. With these advantages, in this study LAB are applied as a biopreservation technique to preserve beef products.
Mostly, LAB can be found in a variety of fermented foods, such as fermented milk products (yogurt, kefir, cheese) and fermented vegetable products (sauerkrauts, kimchi). Dadih is a typical fermented food from West Sumatra, Indonesia, that is originally made from buffalo milk [11]. Previous investigation showed that dadih produced the greatest numbers of LAB colonies compare to those on various types of Indonesian traditional fermented foods [12]. Dadih produced the greatest number of colonies (20 colonies), followed by tempoyak (18 colonies), tamarind (six colonies), and sticky rice tape (two colonies). Several studies demonstrated that LAB isolated from dadih inhibited the growth of pathogenic bacteria such as Salmonella sp., Escherichia coli O157:H7, and Staphylococcus aureus [11]. In addition, LAB also produced antibiotics that suppressed the growth of Listeria monocytogenes [13]. Bacteriocins are prominent antibiotics which have been known as antimicrobial agents in food preservation. Bacteriocins are frequently used with surfactants, such as acids or organic salts, to improve their effectiveness in high-protein foods, such as beef [1,3,14]. LAB strains, such as Lactobacillus plantarum 163 [15] isolated from traditional Chinese fermented vegetables and Lactobacillus curvatus sp. LAB-3H isolated from yogurt [16], have been identified as producing bacterioricins which can be a candidate to control microbial contamination. However, another study showed that bacteriocin also can be degraded by endogenous proteases from the dietary matrix and fat particles in high protein foods [17].
In a previous study, Yuliana et al. discovered that Lactobacillus pentosus 124-2 was identified as the strain of LAB in dadih [18]. CFS containing metabolites from Lactobacillus pentosus 124-2, especially organic acids such as lactate, acetate, citrate, formate, and succinate, may have potential to preserve high-protein foods, such as beef. Therefore, this study aims to investigate the potential effects of metabolites produced from LAB isolated from dadih as biopreservative agents to maintain beef quality and extend its shelf life.
2. Materials and Methods
2.1. Isolation of Lactic Acid Bacteria from Dadih
Dadih was sourced from a dadih producer located in Bukittinggi, a region in West Sumatra, Indonesia. The isolation of lactic acid bacteria was conducted in accordance with the methodology employed by previous studies [19]. The dadih sample was then diluted at 10−1–10−8 dilutions in 0.85% NaCl solution and 1 mL of each 10−3 to 10−8 dilution was taken and transferred into sterile petri dishes. After that, 1% (w/v) CaCO3 was added to the MRSA medium (Merck; Darmstadt, Germany) and incubated at 37 °C for 48 h.
2.2. Production of CFS (Cell-Free Supernatants) from Lactic Acid Bacteria
The screening process of the CFS followed the procedures from the previous studies, with some modifications [20]. The LAB isolate was cultured in the MRSB medium for 18 h at 37 °C after being inoculated with up to 1 inoculating loop. Centrifugation at 6000 rpm for 30 min at 4 °C, followed by pellet separation to create supernatant, was used to harvest the cells. The LAB isolates were identified by the formation of a clear zone around the colony. After that, the colonies were streaked to produce a single colony. To obtain pure/single isolates, single colonies were scratched on MRS agar. Gram staining and the catalase test were used to identify the resulting single isolate qualitatively. LAB isolates were pure isolates that were Gram (+) and catalase (−) positive but not motile [19].
2.3. Lactic Acid Bacteria CFS Antimicrobial Activity Test
The antimicrobial activity test was carried out using the paper disk diffusion method, based on the size of the inhibition zone formed against the test bacteria [13]. Pathogenic bacteria such as Salmonella sp. and E. coli were used as controls in this study. These are classified as Gram positive and Gram negative, respectively, and are common pathogenic bacteria found in food contamination. The pathogenic bacteria were spread on the surface of solid MHA media in quantities up to 100 µL. Sterile disc paper (6 mm) was dipped in the test sample before being placed on the prepared MHA surface. The clear zone formed was then observed after 24 h of incubation at 37 °C.
2.4. Test of Lactic Acid Bacteria Resistance to Acids, Bile Salts, and Temperature
Characterization was carried out by testing acid resistance (pH 2–4), bile salt concentration at 0.3%, and temperature at 25 °C, 37 °C, and 45 °C. Acid resistance testing was carried out by growing 1 inoculating loop of LAB isolate on MRSB media that had been added with 0.1 N HCl until it reached pH 2, 3, and 4 [21]. Bile salt resistance testing was carried out by growing 1 inoculating loop of LAB isolate on MRSB media to which 0.3% (v/w) ox-bile media had been added [21]. Furthermore, the isolates in each medium were incubated at 37 °C for 24 h. The temperature resistance test was carried out by incubating 1 inoculating loop of LAB isolate on MRSB media at a temperature of 25 °C; 37 °C; 45 °C. After incubation, the number of microbes that grew was calculated using the Total Plate Count (TPC) method. Isolates grown on MRSB media and incubated at 37 °C were used as controls.
2.5. Auto-Aggregation and Co-Aggregation Ability Test
After incubating for 24 h, LAB isolates in MRSB were harvested for 10 min at 6000 rpm. The precipitate was then washed with cold Phosphate Buffer Saline (PBS), yielding an OD600 nm of 0.6 (Abs-initial). After incubating the suspended solution at room temperature for 4 h, the final absorbance (Abs-final) was measured at 600 nm. The following equation is used to calculate auto-aggregation [22]:
Auto − agregation (%) = AbsFinal × 100 AbsInitial
The percentage reduction in absorbance of the mixed suspension compared to the individual suspensions is expressed as co-aggregation. LAB and indicator bacteria were mixed in equal parts and vortexed for at least 30 s. The mixture was then stored at room temperature for 4 h, with the absorbance value at 600 nm measured every hour. Each suspension’s absorbance value was also determined individually. Co-aggregation is calculated as follows [22]:
Co − aggregation (%) = [1 − (AbsLAB + AbsPatoghen) − AbsMixAbsLAB + AbsPatoghen × 100
2.6. Beef Biopreservation Test with CFS
The beef samples utilized in this study were sourced from the market, and consisted of chuck cuts obtained from cattle slaughtered within a 9-h timeframe. The beef samples were immersed in sterile petri plates containing cell-free supernatant (CFS) derived from lactic acid bacteria (LAB) for a duration of 30 min within a laminar environment [17]. The beef was subsequently enclosed using polypropylene (PP) plastic fasteners. The beef was subjected to a refrigeration temperature of 4 °C for a duration of 9 days, with regular monitoring occurring every 24 h. In order to assess the beef’s quality, a series of microbiological analyses, including Total Plate Count and E. coli, as well as physical examinations, such as pH and color, were conducted.
2.7. Physical Analysis of Beef
Color and pH analysis were carried out to determine physical changes in meat during storage. Color analysis was carried out on meat that had been cut and visually compared with the meat color standard in SNI 3932:2008 (6). The pH value of meat was obtained from observations using a pH meter that had been calibrated using a pH 7 (7) buffer solution. Meat whose color had been observed was then checked for its pH value by placing the tip of the pH meter sensor on the meat. This treatment was carried out every 24 h for 9 days.
2.8. Data Analysis
This study used experimental and descriptive analysis. All experiments in this study were repeated twice, and the results were expressed as mean standard deviation (SD). The increased numbers of total microbes and E. coli during beef storage were studied using regression analysis. The collected data were then analyzed descriptively.
3. Results
3.1. Isolation of Lactic Acid Bacteria from Dadih
In this study, we investigated the presence of lactic acid bacteria (LAB) candidate isolates in dadih by utilizing dilutions of 10−3 and 10−4. Five bacterial isolates, namely DK1–DK5, were examined for this purpose. Subsequently, a series of qualitative tests were conducted, including Gram staining, catalase testing, and assessment of motility. The findings of the catalase test indicated a negative outcome for all five isolates. After conducting the Gram staining test on the five isolates, it was seen that isolates DK1, DK2, and DK3 exhibited the most pertinent outcomes, thereby establishing them as potential candidates for LAB (lactic acid bacteria) isolation (see Table 1).

Table 1.
The results of qualitative identification of lactic acid bacteria, 296 × 109 mm (38 × 38 DPI).
Upon observation of the cell morphologies (stems), it was determined that the cells of the five isolates had bacilli morphology. The locomotive capacity of the bacteria was subsequently evaluated in order to ascertain the presence of flagella. Positive test results were observed when there was visible development surrounding the puncture marks caused by the LAB colony. This was achieved by introducing one inoculating loop of LAB into the MRSA medium. The results of the experiment indicate that the movement tests conducted on all three isolates yielded negative outcomes, hence providing evidence to support the absence of flagella in the bacteria.
3.2. Lactic Acid Bacteria CFS Antimicrobial Activity Test
The test microorganisms, E. coli and Salmonella sp., were employed to assess the antibacterial efficacy of the cell-free supernatant. The disc diffusion method was employed to conduct the test, and the findings presented in Table 2 demonstrate that each isolate exhibited distinct mechanisms of inhibition against the test bacterium.

Table 2.
The results of CFS antimicrobial activity test, 294 × 123 mm (38 × 38 DPI).
The cell-free supernatant (CFS) produced by LAB was subsequently subjected to testing in order to determine its bactericidal efficacy against the isolates DK1, DK2, and DK3. Among the three isolates of lactic acid bacteria, it was observed that the DK1 isolate exhibited the most pronounced antibacterial metabolite activity against E. coli (13 mm) and Salmonella sp. (11.5 mm). The following table presents the data collected in Table 2. The Salmonella sp. exhibited an inhibition zone of 9.5 mm in width, while the E. coli strain had an inhibition zone measuring 8.5 mm in width. Finally, the DK3 isolate exhibited an 8 mm diameter zone of inhibition against Salmonella sp. and an 8.5 mm diameter zone against E. coli.
3.3. Characterization of Probiotic Candidate Lactic Acid Bacteria
Probiotic bacteria have the capacity to produce various bioactive compounds that possess the ability to inhibit the proliferation of pathogenic bacteria. Probiotic microbes are the primary source of LAB. The probiotic candidates underwent characteristic testing in order to provide further evidence for the previously shown antibacterial activity, wherein the DK1 isolates exhibited the most prominent clear zones. In order to flourish within the gastrointestinal system, probiotic bacteria must possess antibiotic properties and exhibit resistance to low pH levels (2–3) as well as bile salts [22]. In addition, it is imperative to assess the capacity of probiotic bacteria to engage in auto-aggregation, which refers to the aggregation with similar bacteria, as well as co-aggregation, which pertains to the aggregation with dissimilar bacteria. This examination is crucial for their viability within the gastrointestinal tract and their ability to counteract harmful bacteria [23]. The bacteria DK1, referred to as the control isolates, were grown in MRSB media and incubated at 37 °C for a duration of 24 h. The results of the LAB characterization test demonstrated that the bacterial isolate DK1 exhibited the ability to thrive in an environment with a bile salt content of up to 7.99 log CFU/mL, as depicted in Figure 1.

Figure 1.
Graph of LAB growth in characterization of probiotic candidates, 264 × 216 mm (59 × 59 DPI).
In addition, the DK1 bacterial isolates have been seen to exhibit resilience to acidic pH conditions, with the ability to survive at pH values as low as pH 2 and up to 6.15 log CFU/mL. Additionally, the results indicated that the bacteria exhibited a production of six logarithmic colony-forming units per milliliter (log CFU/mL) at temperatures of 25 °C, 37 °C, and 45 °C. The DK1 isolates exhibited a commendable performance on the auto-aggregation test, achieving a score of 89.2% (Table 3).

Table 3.
Lactic acid bacteria auto-aggregation and coaggregation test results, 298 × 68 mm (38 × 38 DPI).
In order to establish a presence and thrive within the gastrointestinal tract, probiotic bacteria must possess the ability to undergo auto-aggregation [23]. Salmonella sp. and E. coli bacteria were utilized in co-aggregation investigations. The co-aggregation test results demonstrated a higher percentage of co-aggregation with E. coli bacteria (53.1%) compared to Salmonella sp. (46.9%) (Table 3). Certain pathogenic bacteria and lactic acid bacteria possess the ability to induce coagulation, hence facilitating the release of antibiotic substances into the targeted cells of the pathogens. This mechanism allows the bacteria to effectively control the growth and proliferation of potentially pathogenic bacteria in close proximity [23]. Co-aggregation has the potential to hinder the colonization of harmful bacteria on the intestinal mucosa, while also facilitating the production of antibiotic substances, hence enhancing the eradication of pathogenic microorganisms from the digestive system.
3.4. Effect of Addition of CFS LAB on Beef Quality
3.4.1. Microbiology Quality
On the initial day of the experiment, the quantity of microorganisms present in the untreated beef sample was recorded as 5.30 log CFU/g. In contrast, the beef sample treated with CFS exhibited a lower microbial count of 4.81 log CFU/g, as depicted in Figure 2.

Figure 2.
Regression graph of changes in the total number of beef microbes during refrigerator temperature storage (4 °C), 276 × 169 mm (59 × 59 DPI).
The numerical value continues to exhibit a steady upward trend until the conclusion of the ninth day of storage. According to the Indonesian National Standards (SNI 3932:2008) [24], the acceptable total plate count (TPC) limits for beef intended for consumption are 1 × 106 colony-forming units per gram (CFU/g) (equivalent to 6 log CFU/g) and 1 × 101 CFU/g (equivalent to 1 log CFU/g), respectively. In contrast to the control beef, which exhibited a log CFU/g count of 5.89 on the initial day, the CFS beef demonstrated the ability to sustain a log CFU/g count of 5.94 until the fourth day, meeting the stipulated requirement outlined in SNI 3932:2008. According to the SNI 3932:2008 standard, it is stipulated that the concentration of E. coli should be 1 × 101 colony-forming units per gram (1 logarithm of colony-forming units per gram). From the initial day of observation, the control beef samples exhibited a presence of 2.73 logarithmic colony-forming units per gram (log CFU/g) of Escherichia coli (E. coli), surpassing the threshold set by the Indonesian National Standard (SNI) 3932:2008. The provided figure, labeled as Figure 3, is presented for reference. The beef samples treated with CFS on day 0 were found to contain an E. coli concentration under the permissible range of 1 log CFU/g. During the initial nine days of storage, there was a gradual decrease in the quantity.

Figure 3.
Regression graph of changes in the total E. coli of beef during refrigerator temperature storage (4 °C), 280 × 168 mm (59 × 59 DPI).
3.4.2. Physical Quality
During the preservation process, an assessment of the meat’s pH and color was conducted as part of a physical functioning examination. The pH level is hypothesized to exert an influence on the proliferation of microorganisms in meat. The pH levels of fresh beef and processed foods that are deemed suitable for ingestion typically range from 4.6 to 6.4 [25]. The hue of meat is also influenced by pH levels. Beef with a high pH is commonly associated with the hue of dark crimson. The pH level of the beef exhibited an increase throughout the initial nine days of both treatments, as depicted in Figure 4. The pH values of the control beef samples were measured to be 6.2 on day 4, 7.15 on day 6, and 7.75 on day 9. The pH of the beef may exhibit variations during the course of treatment, with a recorded value of 6.35 on the seventh day and 6.65 on the ninth day.

Figure 4.
Graph of changes in beef pH during refrigerator temperature storage (4 °C), 278 × 181 mm (59 × 59 DPI).
The beef utilized in this context is derived from the chuck portion. According to the SNI 3932:2008 standard [24], class II beef is defined to encompass chuck beef. Based on the specifications outlined in SNI 3932:2008, it is required that beef exhibits a color quality score falling within the range of 6–7, which corresponds to a dark red hue (see Figure 5).

Figure 5.
Graph of changes in beef color score during refrigerator temperature storage (4 °C), 273 × 177 mm (59 × 59 DPI).
Based on the findings of SNI 3932:2008, it was observed that both the control beef and the beef with CFS had a dark red color on day 0. The coloration of the meat is typically more intense in the control group. The hue of the beef underwent a darkening process as it was held for an extended duration, specifically until the ninth day. Between the sixth and ninth day, there was an observable alteration in the color of the control beef, which transitioned to a deeper shade of red. The stability of the color change in beef subjected to CFS therapy remained consistent until the ninth day, as depicted in Figure 5.
4. Discussion
4.1. Isolation and Characterization of Probiotic Candidate Lactic Acid Bacteria from Dadih
The presence of Ca-lactate is shown by the formation of a clearly defined zone surrounding the colony. This zone is formed as a result of the combination of primary metabolites produced by lactic acid bacteria, namely lactic acid and organic acids, along with CaCO3. Figure 6 displays an isolate that exhibited a distinct zone encompassing the colony.
Figure 6.
Lactic acid bacteria isolate from dadih showing clear zone on MRSA + CaCO3 1% (w/v) media, 180 × 155 mm (59 × 59 DPI).
Lactic acid bacteria can be classified as Gram-positive bacteria that are negative for catalase activity and lack motility [19]. The qualitative tests conducted on the isolates DK1, DK2, and DK3 indicate the presence of lactic acid bacteria. Furthermore, the metabolites derived from the three probable lactic acid bacteria (LAB) isolates were extracted. The extraction of bacterial liquid culture involved a 24-h incubation period. Subsequently, the bacterial culture underwent centrifugation in order to achieve the separation of the bacteria from their byproducts, which are often referred to as cell-free supernatant (CFS). The antimicrobial effectiveness of the cell-free supernatant from each colony of lactic acid bacteria (LAB) was subsequently assessed against the test pathogens often found in beef, namely E. coli and Salmonella sp. The metabolic byproducts produced by lactic acid bacteria encompass a range of substances such as organic acids, diacetyl, hydrogen peroxide (H2O2), reuterin, antifungal peptides, and bacteriocins [26]. These compounds exhibit potent antibacterial activity. The outcomes of the inhibitory zone’s diameter for each isolate were found to be diverse. Several variables influence the outcome, including the sensitivity of the test microorganisms, the rate at which antimicrobial chemicals diffuse, and the concentration of antimicrobial substances. The outcomes of antimicrobial activity can be classified according to the size of the inhibition zone diameter observed. The inhibitory zones were classified into three categories based on their sizes: faint (+), moderate ++ (3–6 mm), and strong +++ (more than 6 mm) [27]. The diameter of the inhibitory zone was determined by dividing the total diameter by the diameter of the paper disc. The disc paper employed in this study possesses a diameter of 6 mm. Consequently, the inhibitory potency may be classified into three distinct groups, namely weak (+), medium (+), and strong (+), for diameters ranging from 6 to 12 mm. Due to the observed strong and moderate inhibition of E. coli and Salmonella species by the CFS generated by the DK1 isolate, it was deemed necessary to evaluate the DK1 isolate as a potential probiotic candidate bacterium. Additionally, the effects of the CFS produced by the DK1 isolate on the quality of beef during storage were investigated (see Table 2).
The probiotic bacteria exhibit the ability to withstand an acidic environment characterized by a pH range of 2–4, as well as the presence of bile salts at a minimum concentration of 0.3%. The results also indicated that the bacteria exhibited a yield of 6 log CFU/mL at temperatures of 25 °C, 37 °C, and 45 °C. In order to exert an influence on the gut environment, a concentration of probiotic bacterial strains ranging from six to eight logarithmic colony-forming units per milliliter (CFU/mL), or 106–108 CFU/mL, is required [28]. The LAB DK1 isolate has been identified as a potential probiotic candidate based on its ability to survive and proliferate across a wide temperature range of 25 °C to 45 °C, with acidic pH levels ranging from 2 to 4, and a bile salt concentration of 0.3%.
Furthermore, it is imperative for probiotic bacteria to possess the ability to aggregate or cling to the intestinal mucosa alongside both pathogenic and nonpathogenic bacteria, a phenomenon known as co-aggregation [22]. The complicated interaction between cell surface and excretory components is responsible for the formation of the mechanism of cell aggregation. Probiotic bacteria are capable of colonizing the intestinal mucosa throughout the process of digestion due to their ability to adhere to the surface of the intestinal mucosa through the formation of aggregates. Additionally, aggregates serve to inhibit the adherence of pathogenic bacteria to the intestinal mucosa, hence decreasing the presence of pathogenic microorganisms on the mucosal surface. Bacteria were categorized as non-auto-aggregating if their auto-aggregation capacity was below 10% [20]. Based on the obtained data, it can be extrapolated that the DK1 isolate exhibits potential as a probiotic candidate.
4.2. Effect of Addition of CFS from LAB on Beef Quality
The assessment of the microbiological quality of beef can be determined by evaluating the quantity of microorganisms present, notably pathogens. This pertains to the security of beef intake by humans. The two primary microbiological features of food that were commonly examined were the total plate count (TPC) and the count of E. coli. The utilization of biopreservatives has been shown to effectively inhibit the growth and proliferation of microorganisms in food products during the storage period [7]. However, certain bacteria have the ability to thrive in such conditions, thereby mitigating any potential harm. Refrigeration has the capacity to restrict or halt the growth and metabolic processes of microorganisms in food. The beef samples subjected to CFS treatment for a duration of 30 min on day 0 exhibited reduced microbial proliferation compared to the control beef samples in both the overall microorganism count and specifically in the presence of E. coli. Based on the provided information, it may be inferred that CFS exhibits antibacterial properties against microorganisms present in cattle. The survival rate of bacterial populations in beef is typically influenced by various environmental factors, such as the composition of the growth medium, temperature, pH levels, and food availability. Consequently, the duration of beef storage is often associated with the growth and proliferation of bacteria [29].
Throughout the storage period, the growth output of E. coli from both treatments exhibited a consistent decline. The observed outcome could potentially be attributed to the utilization of storage protocols conducted at a relatively low temperature of 4 °C. The decrease in bacterial growth is attributed to cellular damage caused by a temperature shock [29]. E. coli exhibits optimal growth within a temperature range of 10 to 45 °C, with 35 °C being identified as the most favorable temperature for its proliferation [29]. From the initial day of observation, the population of E. coli in the control beef exhibited an increase on day 1, followed by a subsequent decline on each successive day until day 9. This phenomenon is feasible due to the ability of E. coli to endure in low-temperature storage initially. However, once the temperature reaches a stable level of 4 °C, the growth of E. coli is hindered and ultimately ceases. The beef subjected to a CFS treatment exhibited persistence from the initial day of storage to the ninth day. This phenomenon can be attributed, along with the influence of storage temperature, to the utilization of CFS, characterized by a pH value of 3.8, indicating its acidic nature. E. coli is capable of thriving within a pH range of 6.5 to 9.0, with a pH level of 8.5 being considered optimal for its growth. The presence of E. coli bacteria in beef treated with CFS is reduced due to the inhibitory effects or potential prevention of bacterial development below the optimal pH.
The probability distribution for Y exhibits variation with each incremental change in X, as seen by the linear regression equation (Y = 1X + 0), where the slope (1) is a statistical measure [30]. The Y-intercept value of the regression line, denoted as the parameter β0, is equal to zero. The regression analysis of the changes in the number of bacteria (X) suggests a positive relationship between storage time and total microbial count (Y). The R-squared (R2) value of the graph indicates the extent to which the regression model is able to explain the relationships between the variables being studied [30]. R2 levels that are near to one are indicative of favorable results. Based on the results obtained from the regression analysis of microbial growth, it was seen that the slope value of the control beef (0.3962) was greater in magnitude compared to the slope value of the beef subjected to CFS treatment (0.2643). This study illustrates the efficacy of CFS in inhibiting microbial proliferation in meat. The beef samples treated with the addition of CFS exhibited an average increase in microbiological growth of 0.2643 0.26 log CFU/g per day, whereas the control beef samples demonstrated an average increase in microbial growth of 0.3962 0.39 log CFU/g per day. The R2 value of the regression equation pertaining to the beef soaking therapy in chronic fatigue syndrome (CFS) is 0.9704, suggesting that about 97.04% of the variability in the regression model can be accounted for by the included components and their interactions.
Based on the findings of the E. coli growth regression analysis, it was observed that the slope value for the control beef (−0.0604) was comparatively greater than that of the beef subjected to CFS treatment (−0.182). This study illustrates the efficacy of CFS in inhibiting microbial proliferation in beef. The beef samples that were treated with the addition of CFS had an average decrease in E. coli growth of 0.1182 ± 0.12 log CFU/g per day. In contrast, the control beef samples displayed an average decrease in E. coli growth of 0.0604 ± 0.06 log CFU/g per day. The R2 value of the regression equation for the beef soaking therapy in CFS is 0.8466, suggesting that about 84.66% of the variation in the regression model can be accounted for by the interaction of the factors.
The beef used for this study was 9 h post-slaughter at the time of its cutting. Following the process of slaughter, beef undergoes a slow decline in pH levels from an initial value of 7.0 to a range of 5.6–5.7, ultimately stabilizing at a final pH of approximately 5.3–5.7. The decrease in quantity was instigated by the glycolysis process of the meat. This observation indicates that the beef utilized exhibits indications of undergoing the glycolysis process. The biochemical pathway by which glycogen in the muscles of beef is converted into lactic acid by the action of glycogen enzymes, in the absence of oxygen, is referred to as glycolysis. The pH of the beef increased until the ninth day in both treatment groups. According to previous research by Hafid et al. [22], beef exhibits increased microbial growth within the pH range of 6.2 to 7.2. However, it demonstrates enhanced resistance against microbial damage when the pH level falls within the range of 5.1 to 6.1. The olfactory, visual, and tactile properties of beef undergo alterations when reaching a pH of 6.8, which signifies the initiation of protein degradation. The bacteria responsible for the process of decay have the ability to enzymatically degrade proteins, resulting in the production of several malodorous compounds including cadaverine, indole, skatole, mercaptans, amines, and hydrogen sulfide (H2S). The degradation process will result in an elevation in pH due to the weak acidic nature of mercaptans and H2S, the basic properties of indole and skatole, the strong basicity of amines and cadaverine, and the weak basicity of indole and skatole.
Based on the observed pH values, it can be determined that microbial growth exhibited an increase on the fourth day for the control beef, subsequently leading to spoilage commencing on the sixth day. The pH of beef exhibits variability; however, it can be effectively controlled with the application of CFS therapy. The results indicate that microbial growth did not commence until the seventh day, suggesting that the beef with CFS had not undergone spoilage. Color variations occur throughout the duration of the observation, up to its completion. Once the bacterial count reaches a range of 108–109 CFU/mL (equivalent to 8–9 log CFU/g), a noticeable change in color will occur, transitioning from a dark red shade to a greenish hue. Metmyoglobin is formed as a consequence of the oxidation of myoglobin by hydrogen sulfide (H2S). The color of the control beef transitioned from a vivid red hue to a deeper shade of red between the sixth and ninth day. By the sixth day, the microbial count had reached a level greater than 108 CFU/g or greater than 8 log CFU/g (Figure 3), indicating the presence of bacterial metabolites responsible for the oxidation of beef myoglobin components. This phenomenon could potentially be associated with the observed increase in pH level of the control beef samples. The stability of the color change in the meat subsequent to CFS therapy was consistent until the ninth day. Based on the data presented in Figure 3, it can be observed that the chemicals present in beef myoglobin underwent oxidation when the microbial growth in the beef treated with CFS reached a level of greater than 106 CFU/g or 6 log CFU/g on the seventh day.
It can be concluded that chilling temperature (4 °C) can effectively preserve the microbiological and physical quality of beef for a period of up to nine days by utilizing the controlled fermentation system (CFS) of lactic acid bacteria derived from dadih. The experimental beef exhibited decreased counts of bacteria, specifically E. coli, as well as a reduced pH level compared to the control beef. The stability of color shift in beef treated with CFS was shown to be greater when compared to control meat.
5. Conclusions
This research highlights the potential application of lactic acid bacteria, specifically the DK1 isolate derived from dadih, fermented buffalo milk, as a biopreservative for beef. The DK1 isolate exhibited notable antibacterial efficacy against E. coli and Salmonella sp., alongside advantageous probiotic characteristics including resistance to bile salts, tolerance to a broad range of pH and temperature conditions, and a substantial cell population. The application of the DK1 isolate’s metabolites to beef led to a significant decrease in the occurrence of E. coli and other bacteria, hence improving the quality of the meat by promoting more stable pH levels and inducing a noticeable change in color. The results of this study indicate that the utilization of probiotic lactic acid bacteria derived from dadih as a biopreservative in beef may represent a viable and efficient approach for enhancing the longevity of meat products, as well as enhancing their safety and overall quality.
Author Contributions
Conceptualization, T.Y.; methodology, F.N.T.; software, A.K.; validation, P.W.H.; formal analysis, H.M.; investigation, F.N.T.; resources, Y.C.; data curation, Y.C.; writing—original draft preparation, T.Y.; writing—review and editing, H.M. and P.W.H.; visualization, A.K.; supervision, T.Y.; project administration, H.M.; funding acquisition, P.W.H. All authors have read and agreed to the published version of the manuscript.
Funding
This work was supported by Universitas Padjadjaran Research Grant (Grant Number 1549/UN6.3.1/PT.00/2023).
Institutional Review Board Statement
Not applicable.
Informed Consent Statement
Not applicable.
Data Availability Statement
The data presented in this study are available on request from the corresponding author.
Acknowledgments
We would like to thank Padjadjaran University and the Ministry of Education, Culture, Research and Technology Indonesia for their support for this research.
Conflicts of Interest
The authors have declared no conflict of interest.
References
- Barcenilla, C.; Ducic, M.; López, M.; Prieto, M.; Álvarez, O.A. Application of lactic acid bacteria for the biopreservation of meat products: A systematic review. Meat Sci. 2021, 183, 108661. [Google Scholar] [CrossRef] [PubMed]
- Khalili, S.S.; Aliakbarlu, J.; Tajik, H.; Mahmoudian, A. Anti-listeria activity and shelf -life extension effects of Lactobacillus along with garlic extract in ground beef. J. Food Saf. 2019, 39, 6. [Google Scholar]
- Nath, S.; Chowdhury, S.; Chowdhury, S.; Dora, K.; Sarkar, S. Role of biopreservation in improving food safety and storage. Int. J. Eng. Res. Appl. 2014, 4, 26–32. [Google Scholar]
- Honikel, K.O. The use and control of nitrate and nitrite for the processing of meat products. Meat Sci. 2008, 78, 68–76. [Google Scholar] [CrossRef]
- Beltrán, J.; Bellés, M. Effect of freezing on the quality of meat. Ref. Modul. Food Sci. 2018, 2, 493–497. [Google Scholar]
- Jiménez, C.F.; Herrero, A.M.; Cofrades, S.; Ruiz, C.C. Meat: Eating quality and preservation. In Encyclopedia of Food and Health; Academic Press: Cambridge, MA, USA, 2016; pp. 685–692. [Google Scholar]
- Batiha, G.E.; Hussein, D.; Algammal, A.; George, T.; Jeandet, P.; Al-snafi, A.; Tiwari, A.; Pamplona, J.; Mariana, C.; Thorat, N.; et al. Application of natural antimicrobials in food preservation: Recent views. Food Control 2021, 126, 108066. [Google Scholar] [CrossRef]
- Moradi, M.; Kousheh, S.; Almasi, H.; Alizadeh, A.; Guimarães, J.; Yılmaz, N.; Lotfi, A. Postbiotics produced by lactic acid bacteria: The next frontier in food safety. Compr. Rev. Food Sci. Food Saf. 2020, 19, 3390–3415. [Google Scholar] [CrossRef] [PubMed]
- Daba, G.M.; Elkhateeb, W.A. Bacteriocins of lactic acid bacteria as biotechnological tools in food and pharmaceuticals: Current applications and future prospects. Biocatal. Agric. Biotechnol. 2020, 28, 101750. [Google Scholar] [CrossRef]
- Pisoschi, A.M.; Pop, A.; Georgescu, C.; Turcuş, V.; Olah, N.K.; Mathe, E. An overview of natural antimicrobials role in food. Eur. J. Med. Chem. 2018, 143, 922–935. [Google Scholar] [CrossRef]
- Yuliana, T.; Hayati, F.; Cahyana, Y.; Rialita, T.; Mardawati, E.; Harahap, B.; Safitri, R. Indigenous bacteriocin of lactic acid bacteria from ‘Dadih’ a fermented buffalo milk from West Sumatra, Indonesia as chicken meat preservative. Pak. J. Biol. Sci. 2020, 23, 1572–1580. [Google Scholar] [CrossRef]
- Mustopa, A.Z.; Fatimah, F. Diversity of lactic acid bacteria isolated from Indonesian traditional fermented foods. Microbiol. Indones. 2014, 8, 48–57. [Google Scholar] [CrossRef][Green Version]
- Pato, U.; Yusuf, Y.; Fitriani, S.; Jonnadi, N.; Sri Wahyuni, M.; Feruni, J.; Jaswir, I. Inhibitory activity of crude bacteriocin produced by lactic acid bacteria isolated from dadih against listeria monocytogenes. Biodiversitas 2020, 21, 1295–1302. [Google Scholar] [CrossRef]
- Cleveland, J.; Montville, T.J.; Nes, I.F.; Chikindas, M.L. Bacteriocins: Safe, natural antimicrobials for food preservation. Int. J. Food Microbiol. 2001, 2, 90. [Google Scholar] [CrossRef]
- Hu, M.; Zhao, H.; Zhang, C.; Yu, J.; Lu, Z. Purification and characterization of plantaricin 163, a novel bacteriocin produced by Lactobacillus plantarum 163 isolated from traditional Chinese fermented vegetables. J. Agric. Food Chem. 2013, 47, 11676–11682. [Google Scholar] [CrossRef]
- Heidari, Z.; Ghasemi, M.F.; Modiri, L. Antimicrobial activity of bacteriocin produced by a new Lactobacillus curvatus sp.LAB-3H isolated from traditional yogurt. Arch. Microbiol. 2021, 1, 101. [Google Scholar]
- Zhang, J.; Liu, G.; Li, P.; Qu, Y. Pentocin 31-1, a novel meat-borne bacteriocin and its application as biopreservative in chill-stored tray-packaged pork meat. Food Control 2010, 21, 198–202. [Google Scholar] [CrossRef]
- Yuliana, T.; Pratiwi, A.R.; Zahratunnisa, S.; Rialita, T.; Cahyana, Y.; Harlina, P.W.; Marta, H. Purification and Partial Characterization of a Bacteriocin Produced by Lactobacillus pentosus 124-2 Isolated from Dadih. Appl. Sci. 2023, 13, 4277. [Google Scholar] [CrossRef]
- Sunaryanto, R.; Marwoto, B. Isolation, identification, and characterization of lactic acid bacteria from buffalo milk curd. J. Sains. dan Teknol. Indones. 2013, 14, 228–233. [Google Scholar]
- Tenea, G.N.; Guaña, J.M. Inhibitory substances produced by native lactobacillus plantarum UTNCys5-4 control microbial population growth in meat. J. Food Qual. 2019, 2019, 9516981. [Google Scholar] [CrossRef]
- Ramadhanti, N.; Melia, S.; Hellyward, J.; Purwati, E. Characteristics of lactic acid bacteria isolated from palm sugar from West Sumatra, Indonesia and their potential as a probiotic. Biodiversitas 2021, 22, 2610–2616. [Google Scholar] [CrossRef]
- Hojjati, M.; Behabahani, B.A.; Falah, F. Aggregation, adherence, anti-adhesion and antagonistic activity properties relating to surface charge of probiotic Lactobacillus brevis gp104 against Staphylococcus aureus. Microb. Pathog. 2020, 147, 104420. [Google Scholar] [CrossRef]
- Panjaitan, R.; Nuraida, L.; Dewanti, H.R. Selection of lactic acid bacteria isolates from tempe and tape as probiotic candidates. J. Food Technol. Ind. 2018, 29, 175–184. [Google Scholar]
- SNI 3932:2008; Quality of Carcass and Beef. Indonesian National Standards. Badan Standarisasi Nasional: Jakarta, Indonesia, 2008.
- Hafid, H.; Napirah, A.; Meliana, L. Effect of defrosting on pH, cooking loss and color of frozen bali beef. Proc. Natl. Semin. Anim. Husb. Vet. Technol. 2017, 275–279. [Google Scholar]
- Ghanbari, M.; Jami, M.; Domig, K.J.; Kneifel, W. Seafood biopreservation by lactic acid bacteria: A review. LWT—Food Sci. Technol. 2013, 54, 315–324. [Google Scholar] [CrossRef]
- Pan, X.; Chen, F.; Wu, T.; Tang, H.; Zhao, Z. The acid, bile tolerance and antimicrobial property of Lactobacillus acidophilus NIT. Food Control 2009, 20, 598–602. [Google Scholar] [CrossRef]
- Kimoto, H.; Kurisaki, J.; Tsuji, N.M.; Ohmomo, S.; Okamoto, T. Lactococci as probiotic strains: Adhesion to human enterocyte-like Caco-2 cells and tolerance to low pH and bile. Lett. Appl. Microbiol. 1999, 29, 313–316. [Google Scholar] [CrossRef] [PubMed]
- Rohman, A.; Ijong, F.; Suwetja, I.K. Viability of Edwardsiella tarda and Esherichia coli preserved with glycerol-tryptone soy broth (TSB) kept at freezing temperature. Aquat. Sci. Manag. 2013, 1, 154. [Google Scholar] [CrossRef]
- Basuki, A.T.; Prawoto, N. Regression Analysis in Economics and Business Research. Depok Rajawali Pers. 2015, 1, 1–18. [Google Scholar]
Disclaimer/Publisher’s Note: The statements, opinions and data contained in all publications are solely those of the individual author(s) and contributor(s) and not of MDPI and/or the editor(s). MDPI and/or the editor(s) disclaim responsibility for any injury to people or property resulting from any ideas, methods, instructions or products referred to in the content. |
© 2023 by the authors. Licensee MDPI, Basel, Switzerland. This article is an open access article distributed under the terms and conditions of the Creative Commons Attribution (CC BY) license (https://creativecommons.org/licenses/by/4.0/).